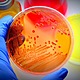
Microbiologia apertura
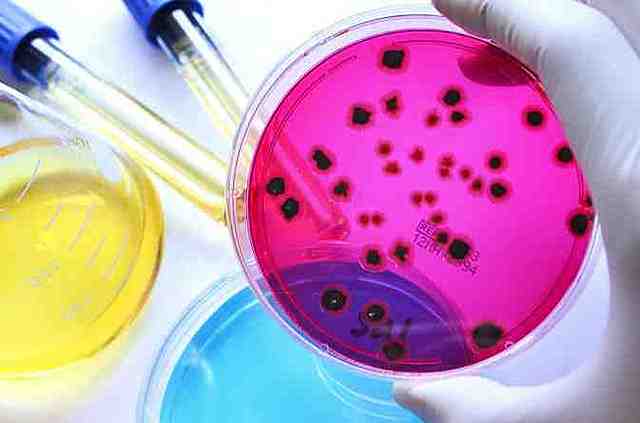
SIGNIFICADO

-
Se dice que Galileo hizo algunas observaciones “microscópicas” invirtiendo su telescopio a partir de lentes montadas en un tubo, pero en cualquier caso está claro que no tuvieron ninguna repercusión. https://www.ugr.es/~eianez/Microbiologia/01historia.htm#_Toc52370965
-
Segundo periodo, de lenta acumulación de observaciones (desde l675 aproximadamente hasta la mitad del siglo XIX), que arranca con el descubrimiento de los microorganismos por Leeuwenhoek. http://microbiologiauasd.blogspot.com/p/blog-page.html
-
(1632-1723) El naturalista holandés Anton van Leeuwenhoek fue el primero en describir, estos organismos (a los que bautizó como “animáculos”), que observó con la ayuda de un microscopio construido por él mismo. https://www.ecured.cu/Microbiolog%C3%ADa#Etapas_de_la_Microbiolog.C3.ADa
-
Desarrolla la primera vacuna contra la viruela humana. https://www.youtube.com/watchv=YlRqeSyN0U8&feature=youtu.be
-
Microbiología deriva de tres palabras de raíz griega, mikro que significa muy pequeño, bios = vida, logos = estudio.
Es la ciencia que estudia los organismos que no se pueden ver a ojo desnudo o simple vista. https://es.wikibooks.org/wiki/Microbiolog%C3%ADa/Historia -
Durante el siglo XIX la atención de muchos naturalistas se había dirigido hacia las diversas formas de animales y plantas que vivían como parásitos de otros organismos. https://www.ugr.es/~eianez/Microbiologia/01historia.htm#_Toc52370965
-
Pasteur demostró que los agentes de la fermentación láctica eran microorganismos, trabajando sobre un problema que había surgido entre los destiladores de Lille cuando en sus cubas la fermentación alcohólica se vio sustituida por una indeseable fermentación láctica. Pasteur identificó distintos microorganismos responsables de diferentes clases de procesos fermentativos. https://www.ugr.es/~eianez/Microbiologia/01historia.htm#_Toc52370965
-
Pasteur publica otro informe en el que explica cómo se pueden capturar los “cuerpos organizados” del aire con ayuda de un tubo provisto de un tapón de algodón como filtro, y la manera de recuperarlos para su observación microscópica. https://www.ugr.es/~eianez/Microbiologia/01historia.htm#_Toc52370965
-
El químico Berthelot había señalado que los microorganismos del suelo podían incorporar nitrógeno molecular directamente del aire. https://www.ugr.es/~eianez/Microbiologia/01historia.htm#_Toc52370965
-
La doctrina del pleomorfismo, mantenía que los microorganismos adoptaban formas y funciones cambiantes dependiendo de las condiciones ambientales.En cambio Koch, Pasteur y Cohn,estaban convencidos de la especificidad y constancia morfológica y fisiológica de cada tipo de microorganismo (monomorfismo). https://www.ugr.es/~eianez/Microbiologia/01historia.htm#_Toc52370965
-
Tercer periodo, de cultivo de microorganismos, que llega hasta finales del siglo XIX, donde las figuras de Pasteur y Koch encabezan el logro de cristalizar a la Microbiología como ciencia experimental bien asentada. http://microbiologiauasd.blogspot.com/p/blog-page.html
-
Cuarto periodo, en el que los microorganismos se estudian en toda su complejidad fisiológica, bioquímica, genética, ecológica, etc., y que supone un extraordinario crecimiento de la Microbiología, el surgimiento de disciplinas microbiológicas especializadas (Virología, Inmunología, etc), y la estrecha imbricación de las ciencias microbiológicas en el marco general de las Ciencias Biológicas. http://microbiologiauasd.blogspot.com/p/blog-page.html
-
Gerhard Domagk, inició un proyecto de búsqueda de nuevos agentes quimioterápicos, siguiendo el esquema de Ehrlich; en 1932-1935 descubre la acción del rojo de prontosilo frente a neumococos hemolíticos dentro del hospedador, pero señala que esta droga es inactiva sobre bacterias creciendo in vitro.
-
Primer periodo, eminentemente especulativo, que se extiende desde la antigüedad hasta llegar a los primeros microscopistas. http://microbiologiauasd.blogspot.com/p/blog-page.html
A list shows items. A timeline shows sequence.
Use Timetoast to make dates, milestones, and turning points easier to understand in a clear visual format. Timetoast is a timeline maker for work, school, research, and stories.